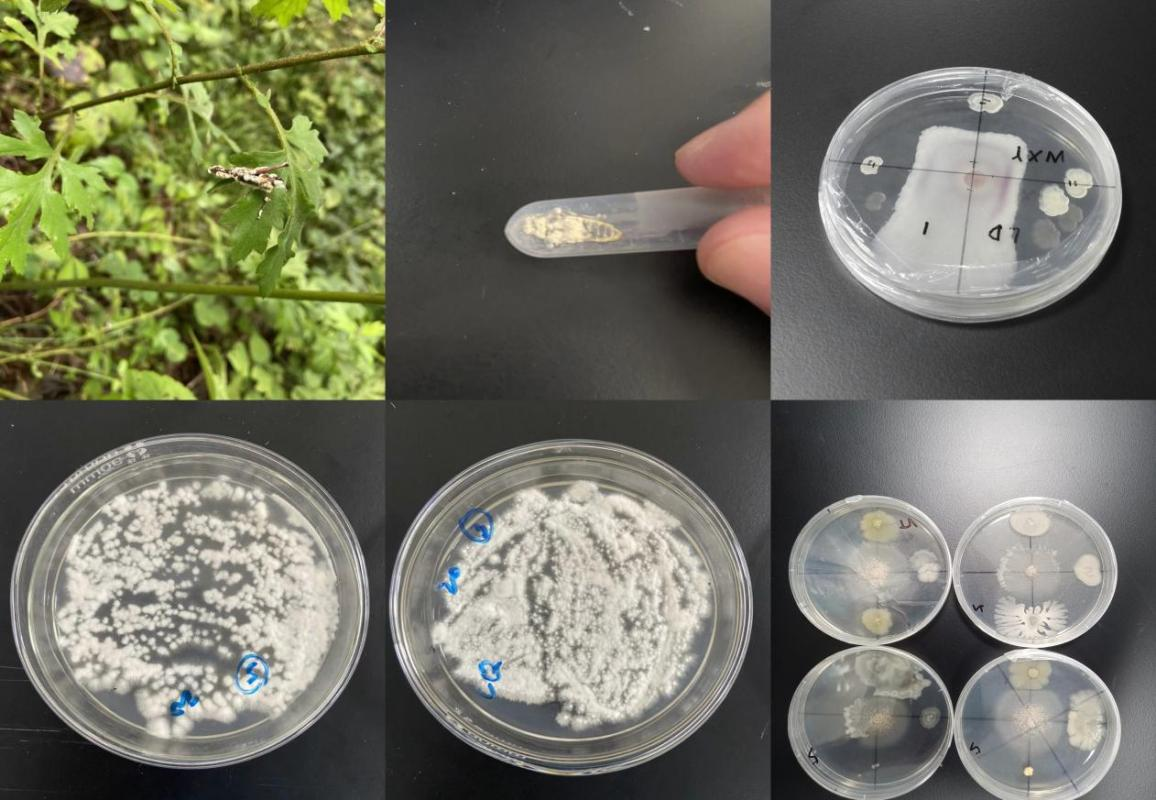

2023年8月21日-9月7日,首届应用生物科学专业2021级28名学生在神农架林区进行了“9+9”的校内外结合的专业基础实习。本次实习由我院黄求应、杨龙、舒少华、蔡青、龚钰华等5位老师具体指导,津田弥生老师参与校内指导。

本次专业实习主要在神龙架林区1000-2000海拔间区域进行动物资源、药用植物、食药用真菌和有益微生物的采集和记录,在校内整理制作、鉴定和描述各类标本,涵盖应用生物资源调查专业技能训练、专业知识培训和相关企业考察。野外资源调查由黄求应、舒少华老师、蔡青和龚钰华4位老师带队开展,由英国365集团神农架科创中心提供后勤保障,采集了丰富的动物资源、药用植物、食药用真菌和有益微生物标本。实习期间,4位指导老师时刻关注学生们的安全和健康状态,关心学生实习进度,与学生一起学习、交流和解答疑惑,让学生对应用生物科学专业的内涵有了更加深入的了解。

除采集资源外,本次实习还参观了神农架林区中医药产业研究院、林投集团珍稀菌基地、神农架汇野生态食品有限公司、神农架生态酒业有限公司四家企业。在神农架林区中医药产业研究院,参观了部分中草药种植大棚和中草药观赏园,并且聆听了舒少华老师对大棚中白及、黄精、淫羊藿等中草药的药用功能、种植技术发展和栽培特点,让同学们对于中草药研究方向有了进一步了解。在林投集团珍稀菌基地,参观了猴头菇、鸡冠菌、灵芝等等珍稀菌的种植生产车间、珍稀菌的低温保存车间和包装车间,以及在他们基地品尝了菌子汤的美味,并由龚钰华老师详细地介绍了各种食药用菌的作用和形态特点。在神农架汇野生态食品有限公司,参观了百花蜜和汇野公司发展史、百花蜜系列产品和土特产展览厅、百花蜜制作原始工具和现代工具等等,并品尝了百花蜜的美味和了解百花蜜制作的不易与珍贵。在神农架生态酒业有限公司四家企业,参观了酿造车间和神农藏酒阁,品尝了神农酱酒,了解了该公司的发展历史和荣誉,从工作人员收获了对于酒业行业相关疑惑的答案。
在这次专业实习中,共采集和记录多花黄精、何首乌、射干等等药用植物70多科、160多种,灵芝、珊瑚菌、木耳等等大型蘑菇60多种,红嘴相思鸟、野猪、米仓山龙蜥、中国林蛙和绿尾大蚕蛾等等鸟类动物、哺乳类动物、爬行类动物、两栖类动物、节肢动物200多种,发现和采集植物叶斑病、白粉病等植物病害标本,并在昆虫和土壤标本中分离培养出白僵菌、木霉菌等细菌和真菌。

实习结束前,学生们对实习成果进行了展览,植科院副院长罗朝喜教授和梅之南教授等几位专家莅临现场指导。展览会上,各组学生分别对实习成果和作品进行了简要介绍。罗院长对实习成果和报告给予了充分的肯定,并表达了对应用生物专业前景的期待。梅之南教授称赞了学生们在中草药标本采集和制作方面的成果,并建议将其中的珍稀中草药标本进行长期保存。展会之后,同学们依据老师们提出的建议又对部分标本进行了精细化处理,并完成了分类保存。

此次专业实习贴近现代农业和生物学对生物资源调查的发展需要,培养了同学们对野生生物资源的辨别、采集、保存和分类等方面的基础理论知识和基本技能,锻炼了同学们吃苦耐劳、积极进取和勇于拼搏的精神品质,为完成发展符合国家现代农业发展需求、高素质复合型新农科应用型人才的目标,走出了具有里程碑意义的关键一步。
文字:满俊杰、蔡青、龚钰华、李翔
图片:李翔、2021级应用生物科学专业学生
审核:黄求应


